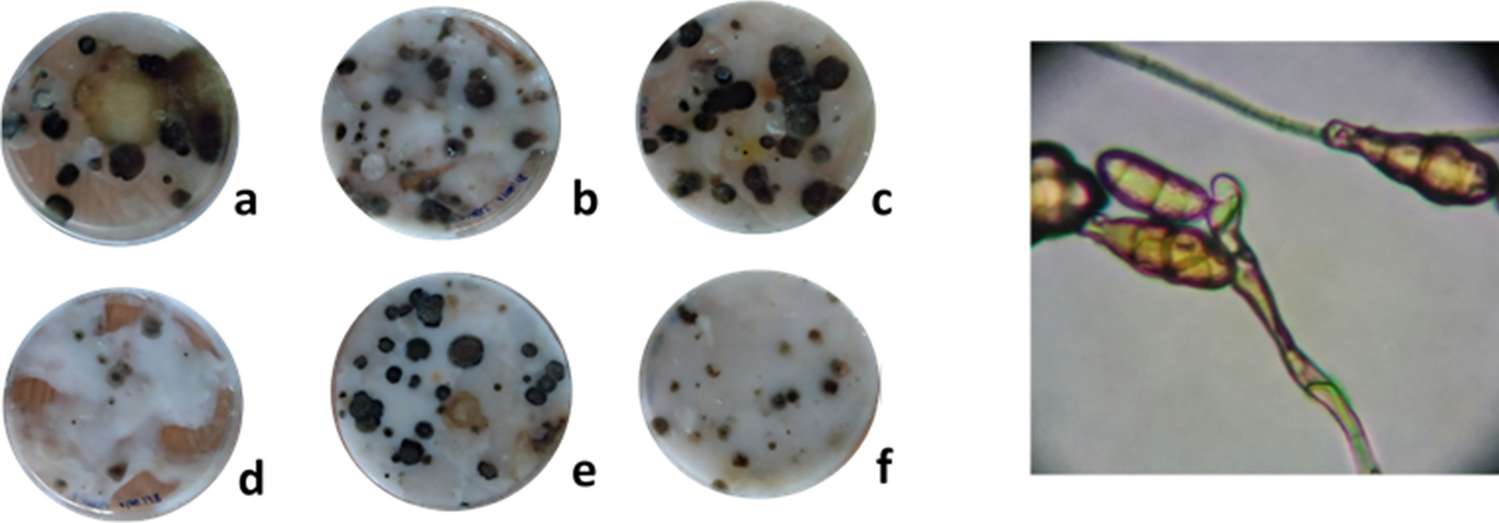
Figure 3

Figure 3
From: A first evaluation of the usefulness of Kudzu starch in cultural heritage restoration
Image of the growth of microorganisms in the different starches. (a) Sigma-Aldrich rice, (b) Lineco wheat, (c) Lineco rice, (d) Kudzu, (e) Sigma-Aldrich corn and (f) Sigma-Aldrich wheat. In the right, image of Alternaria fungus which was found in all the samples.
